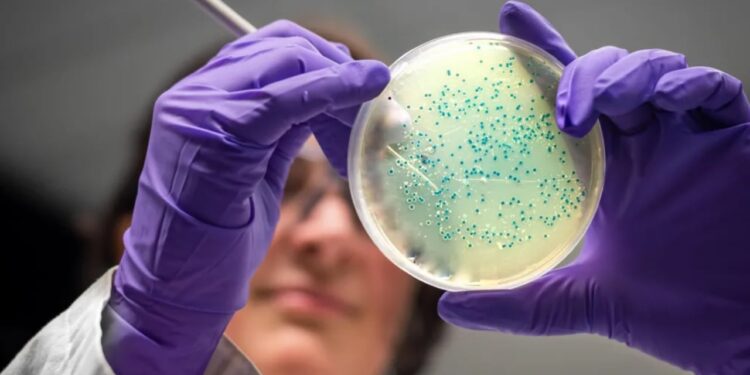

Shkencëtarët e Massachusetts Institute of Technology (MIT) kanë arritur një përparim të rëndësishëm në luftën kundër bakterieve rezistente ndaj antibiotikëve përmes zhvillimit të dy antibiotikëve të rinj, të cilët janë krijuar plotësisht nga inteligjenca artificiale. Këto barna janë të dizajnuara për të trajtuar infeksione të rrezikshme si gonorrea rezistente dhe MRSA (Methicillin-resistant Staphylococcus aureus), të cilat përbëjnë kërcënime serioze për shëndetin publik.
Sistemi gjenerues i AI-së ka ndihmuar në krijimin e këtyre antibiotikëve duke e dizajnuar çdo atom, rezultatet e të cilave kanë qenë premtuese në testet laboratorike dhe në eksperimentet me kafshët. Ekipi i MIT beson se ky mund të jetë fillimi i një “epoke të dytë të artë” në zbulimin e antibiotikëve, një fushë që kohët e fundit është përballur me vështirësi të mëdha në krijimin e barnave të reja. Megjithatë, shkencëtarët theksojnë se këto antibiotikë janë ende në fazat e hershme të zhvillimit dhe kanë nevojë për më shumë rafinim dhe teste klinike përpara se të bëhen të disponueshëm për pacientët.
Rezistenca ndaj antibiotikëve përbën një nga kërcënimet më serioze globale për shëndetin, duke shkaktuar mbi një milion vdekje çdo vit. Probleme si mungesa e antibiotikëve të rinj janë përballur me kërkuesit për dekada, dhe zhvillimet e MIT ofrojnë shpresë të re. Ndryshe nga studimet e mëparshme që përdorin AI për të analizuar kimikate ekzistuese, këta shkencëtarë kanë përdorur teknologjinë për të krijuar molekula të reja me potencial antibakterial nga e para.
Nga 36 milionë komponime të analizuara, vetëm disa janë sintetizuar dhe testuar, duke rezultuar në dy kandidatë të fortë për antibiotikë të reja. Megjithatë, ekspertët theksojnë se procesi i testimit të sigurisë dhe efektivitetit të këtyre antibiotikëve do të jetë një sfidë e gjatë dhe e kushtueshme, e cila përfshin shumë vështirësi shkencore dhe ekonomike.